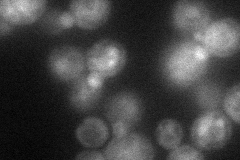
YBR015C
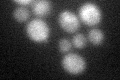
YBR015C
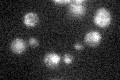
YBR015C

View description
Alpha-1,2-mannosyltransferase, responsible for addition of the first alpha-1,2-linked mannose to form the branches on the mannan backbone of oligosaccharides, localizes to an early Golgi compartment
Localization:
Intensity:
Fold change:
Significance:
-
C’ GFP library in SD

punctate30.21 -
N' NOP1pr-GFP in SD
ER,vacuole58.1612 -
N' TEF2pr-mCherry in SD

vacuole21.9411 -
N' NATIVEpr-GFP in SD

punctate72.5079 -
N' TEF2pr-VC and Cyto-VN in SD

#N/A0 -
C’ GFP library in SD+DTT
punctate16.480.54Yes -
C’ GFP library in SD+H2O2

punctate25.820.85No -
C’ GFP library in Starvation Media
punctate21.710.71Yes -
C’ GFP library on the background of Pup2-DaMP

punctate -
C’ GFP library on the background of CCT mutant

punctate23.58560.780424No
